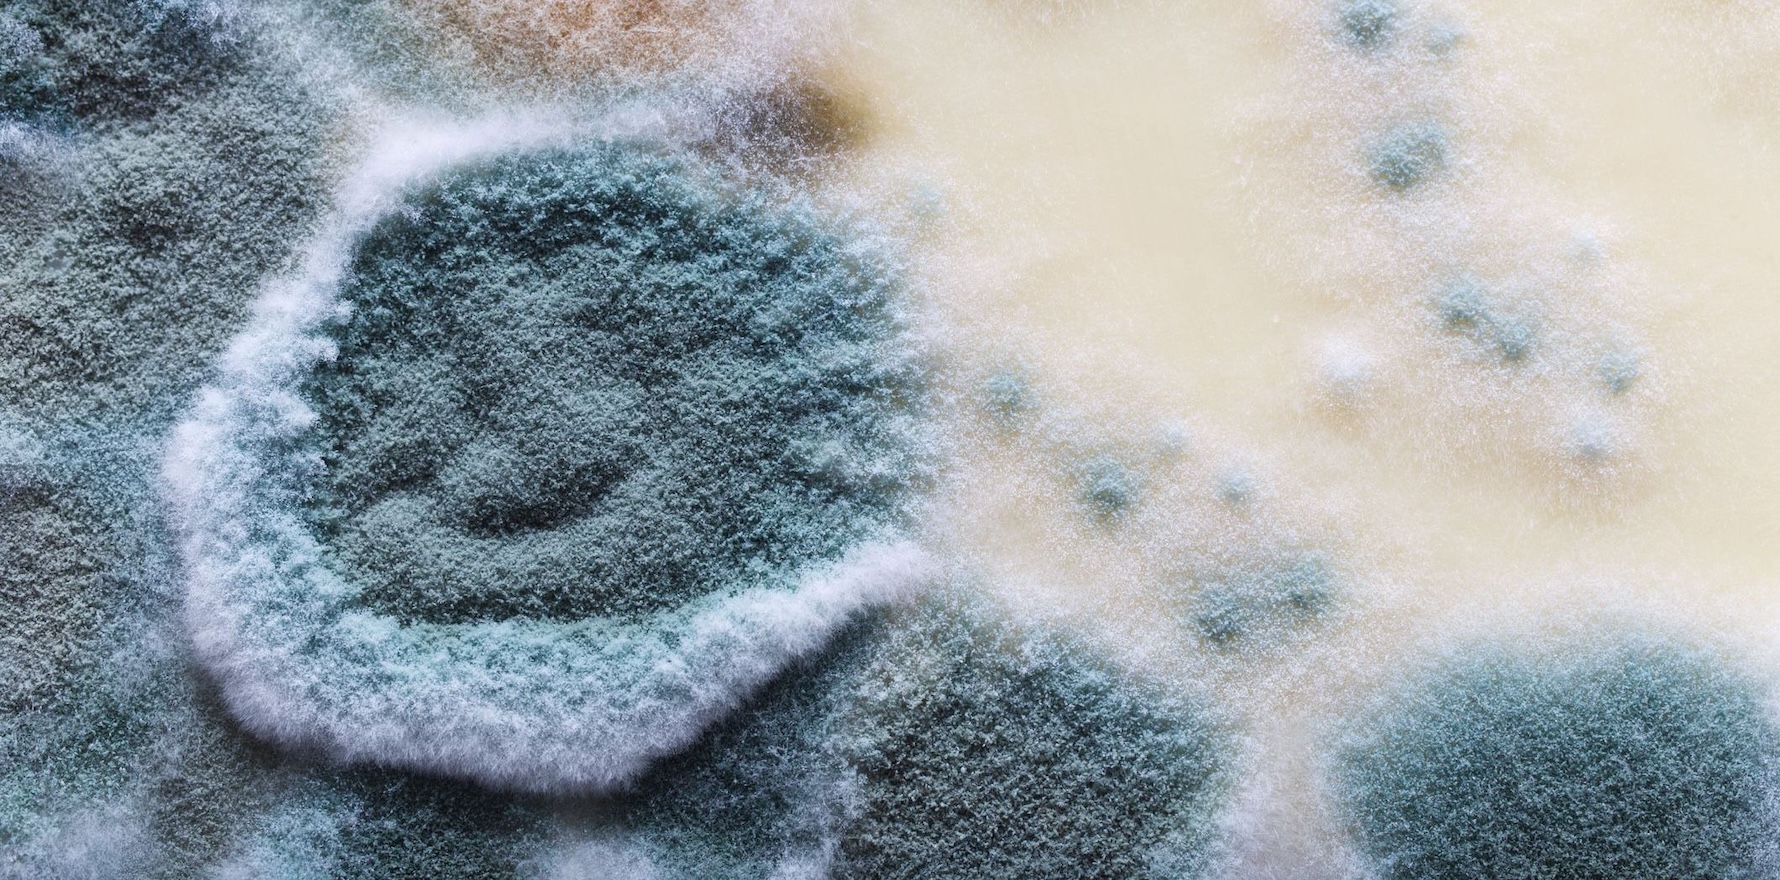

The NSW opposition and the Greens have got their way, despite objections from the state government.
The Calvary Mater Hospital in Newcastle will be the subject of a NSW Parliamentary inquiry after the Coalition rammed it through on Wednesday with the support of the Greens.
Calvary Mater – a private-public partnership between NSW Health and Calvary Health – has been under fire recently after two wards had to be closed down in January due to dangerous mould in the air-conditioning ducts and maggots falling onto patients from vents in the ceilings.
The Labor government did not support the push for an inquiry, despite health minister Ryan Park being critical of the PPP last week.
“This is not a model that the premier or I or the treasurer would want to see happen again in New South Wales,” he said.
“It’s a model I’ve got, and I’ve got to be able to try and work it through, even though there are other operators operating that hospital. So it is complex in nature.
“I am prepared to continue to engage with the staff on this, but I want the community to know we are taking active steps to get this resolved as quickly as possible at all levels.”
Related
Now, the minister will have the help of an inquiry, whether he wants it or not.
According to the Newcastle Herald, the inquiry will look at management, maintenance and operational issues at the hospital, including a specific focus on the “causes and management of incidents involving mould, water damage, pest infestations”.
The inquiry will also look at the effectiveness of the PPP model at the hospital.
Greens health spokeswoman and committee chair Dr Amanda Cohn said Mr Park and the NSW government had a “strong stance” on PPPs in healthcare.
“Unfortunately, they are not walking the talk on this hospital,” she said.
“I hope they walk the talk and end this PPP, but in the meantime this inquiry is a really important piece of work that can help unpick this mess in terms of what went wrong.”